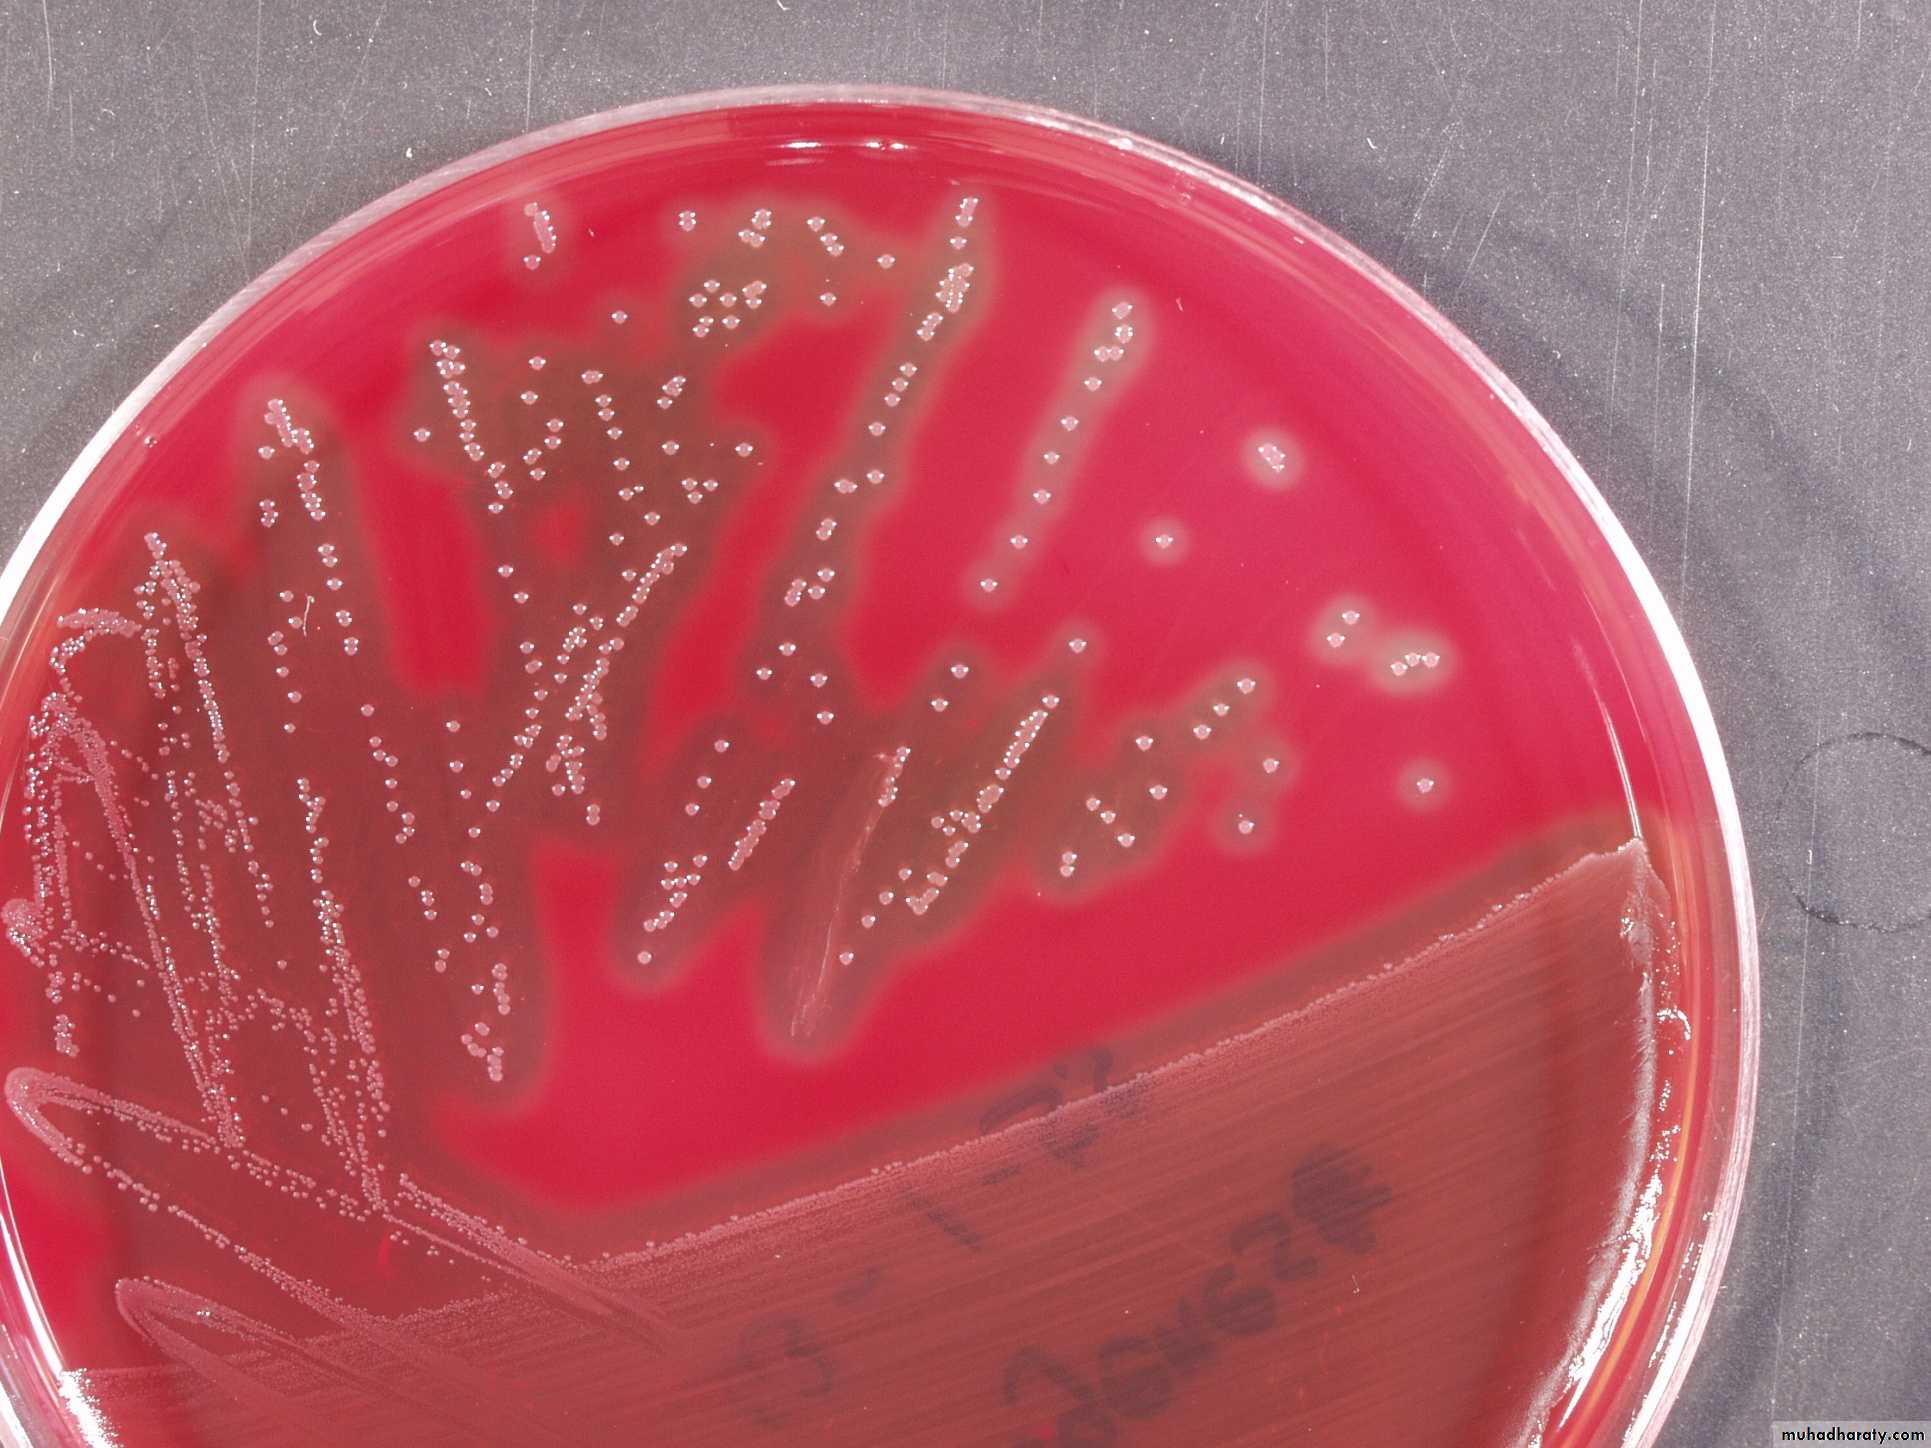
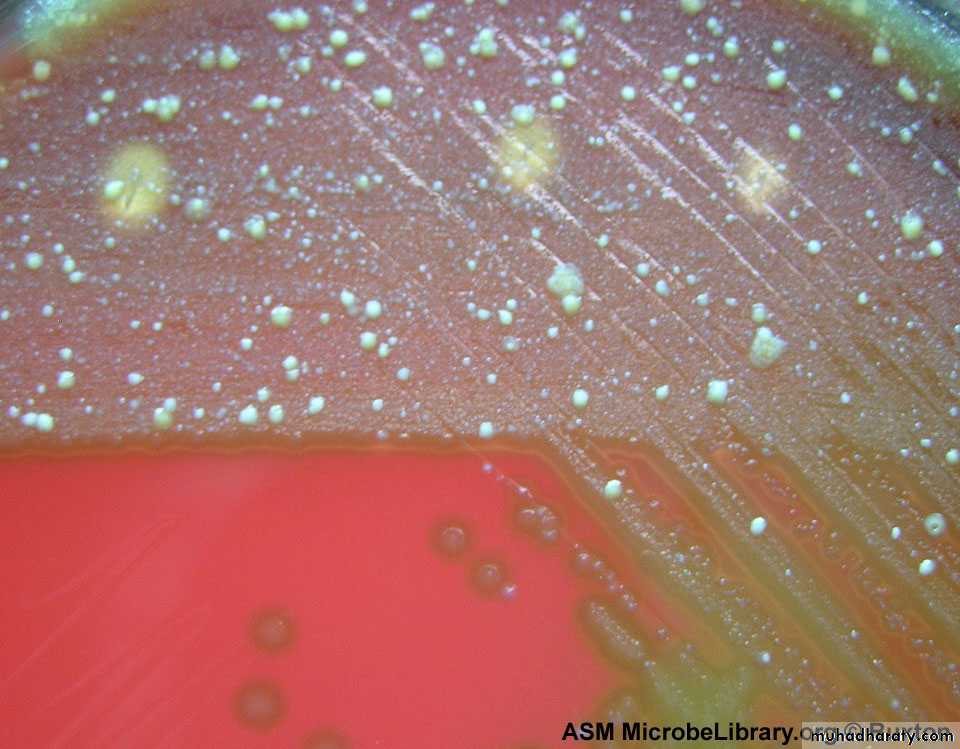
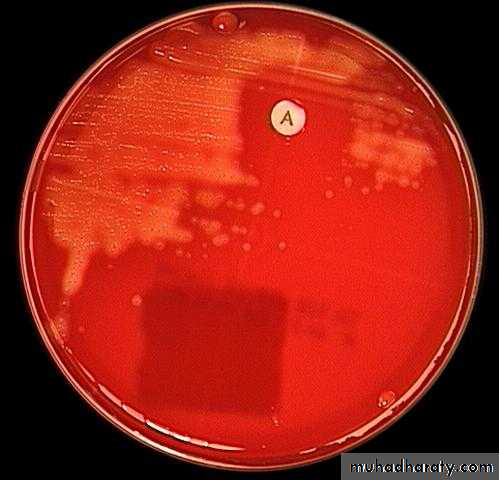
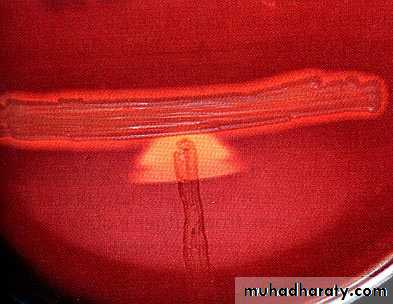

Genus Streptococcus
Gram’s positive, Catalase negative cocci• Department of Microbiology
• College of Medicine
• University of Baghdad
• Lec2, 2013-2014
• Dr.Sarmad M. Zeiny
Objectives: Upon completion of this lecture, the student will:
• Outline the medically important streptococci species.• Classification of genus streptococci.
• Describing the morphology & physiology for streptococci.
• Determine the virulence factors for streptococci.
• Analyze the diseases & pathogenicity for streptococci.
• Demonstrate the epidemiology/transmission for streptococci.
• Outline the laboratory diagnosis for streptococci.
• State the drug of choice and prophylaxis where regularly used.
General characteristic for genus streptococci :
G+ve cocci, arrange in chains or pairs.
Some strains are capsulated
Majority are facultative anaerobic, few are obligatory anaerobic.
Catalase –ve
Non motile.
Non spore forming
Fastidious microorganism
S.pyogenes on blood agar (beta hemolysis)
(Beta hemolysis)clear zone around colonies
Alpha hemolysis (green discoloration)
S.pyogenes (Group A β- hemolytic,GABH):M-protein
80 serotypes
Reservoir
Human throat and skinTransmission
Spread by respiratory droplets or direct contact
Virulence factors & Pathogenesis for S.pyogenes
• M protein• Streptolysin O: destroys RBC & WBC, antigenic. anti-streptolysin O (ASO) antibodies develop.
• Streptolysin S: destroys RBC, not antigenic.
• Pyrogenic exotoxin (erythrogenic toxin): few strains, scarlet fever, few strains superantigens. streptococcal toxic shock syndrome
• Streptokinase plasmin breaks fibrin spreading factor
• Hyaluronidase spreading factor
• Streptodornases (DNAases) spreading factor
• (Anti-C5a) peptidase anti-inflammatory
ASO test:
Measure Ab against Streptolysin O
ASO test uses in poststreptococcal infection. This test used to determine significance of current streptococcal infection by measuring the ASOT:
ASOT (Ab Titer):
Normal < 200 > significance result
DISEASES of S.pyogenes
Acute Tonsillitis
Streptococcal pharyngitis
Impetigo
Erysipelas
Scarlet fever
RHEUMATIC FEVER
• Picture John Travolta in the movie Rheumatic Fever, the upcoming sequel to Saturday Night Fever. His heart is damaged from the stress of the hours of disco dancing, his joints are aching from dropping to his knees, and his arms are moving rhythmically in a disco choreiform jam.
Acute post-streptococcal glomerulonephritis:
Tea colored urine
Acute post-streptococcal glomerulonephritiscauses Coca-Cola colored urine (hematuria) and puffy face
Laboratory Diagnostic steps
Lab dx.:Specimens: sputum, throat swab, nasopharyngeal swab, blood, CSF…etc.
Gram stain: G+ve cocci, arrange in chains.
Culture: on blood agar pinpointed, Grayish white, translucent, matte or glossy colonies with large zone of β- hemolysis.
Bacitracin disc (0.04 U) sensitive causes zone of growth inhibition.
PYR +ve: rapid test, pink is positive.
Serology:
• The rapid strep test (ELISA-based).
• Lancefield grouping, M-protein serotyping.
• ASO test (Antistreptolysin-O test): measure Ab titer.
ASO test:
Measure Ab against Streptolysin O
ASO test used in suspected case of rheumatic fever.
This test used to determine significance of current streptococcal infection by measuring the ASOT:
ASOT (Ab Titer):
Normal < 200 > significance result
Gram stain: G+ve cocci, arrange in chains.
S.pyogenes on blood agar (beta hemolysis)
Bacitracin-disk-test-for-Streptococcus-pyogenes
Zone of inhibitionPYR test
+S.agalactia(Group B β- hemolytic):
Diagnostic featuresHippurate Hydrolyses
للاطلاع
cAMP test
Enterococcus(E.faecalis, E.faecium)
BILE ESCULIN test
للاطلاعNon-enterococcus
(Streptococcus bovis, Streptococcus equinus ):Question?
Differentiate between Group B & Group A Streptococci?Question?
• Give 2 organisms with PYR test positive.
Clinical Questions
?Quinsy (peritonsillar abscess)
Strawberry tongue
fursummary
• Streptococci classified according to the type of hemolysis & antigenic components.
• S.pyogenes is the most pathogenic species because of their virulent factors.
• S.pyogenes can cause post-infection severe complications.
• ASO test used in suspected case of rheumatic fever.
• Streptococci easily diagnosed in the lab. By using Gram’s staining, culture and biochemical tests.
• S.agalactia is the leading Cause for neonatal sepsis, pneumonia & meningitis.
• Enterococcus Causes UTI, biliary tract infection, wound infection, bed sore, endocarditis.
• streptococci infections can be prevented by regular hygiene precautions and by antibiotics, no vaccine.